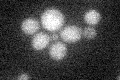
YIL125W
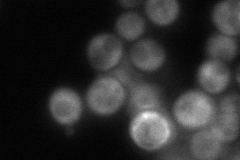
YIL125W
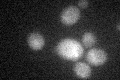
YIL125W

View description
Component of the mitochondrial alpha-ketoglutarate dehydrogenase complex, which catalyzes a key step in the tricarboxylic acid (TCA) cycle, the oxidative decarboxylation of alpha-ketoglutarate to form succinyl-CoA
Localization:
Intensity:
Fold change:
Significance:
-
C’ GFP library in SD
below threshold16.55 -
N' NOP1pr-GFP in SD

mitochondria138.786 -
N' TEF2pr-mCherry in SD

mitochondria201.587 -
N' NATIVEpr-GFP in SD
cytosol79.8347 -
N' TEF2pr-VC and Cyto-VN in SD

#N/A0 -
C’ GFP library in SD+DTT
cytosol15.210.91No -
C’ GFP library in SD+H2O2

cytosol17.891.08No -
C’ GFP library in Starvation Media

cytosol16.911.02No -
C’ GFP library on the background of Pup2-DaMP

below threshold -
C’ GFP library on the background of CCT mutant

below threshold19.42091.17227No
